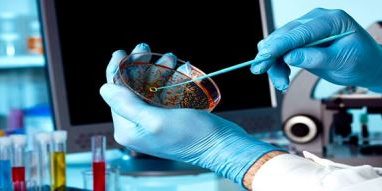

KFOR-i po vazhdon projektet edukuese për të rinj përmes projekteve të CIMIC-ut
Ekipi Ushtarak dhe Civil (CIMIC) i KFOR-it në bashkëpunim me Kolegjin Ndërkombëtar të Biznesit në Mitrovicë (IBCM) do të organizojnë kurse të gjuhës shqipe dhe serbe, pa pagesë. Bashkëjetesa dhe bashkëpunimi i fortë në mes të komuniteteve të ndryshme në Kosovë rezulton me projekte të dobishme, nga të cilat përfiton e gjithë shoqëria, pa asnjë…
Details